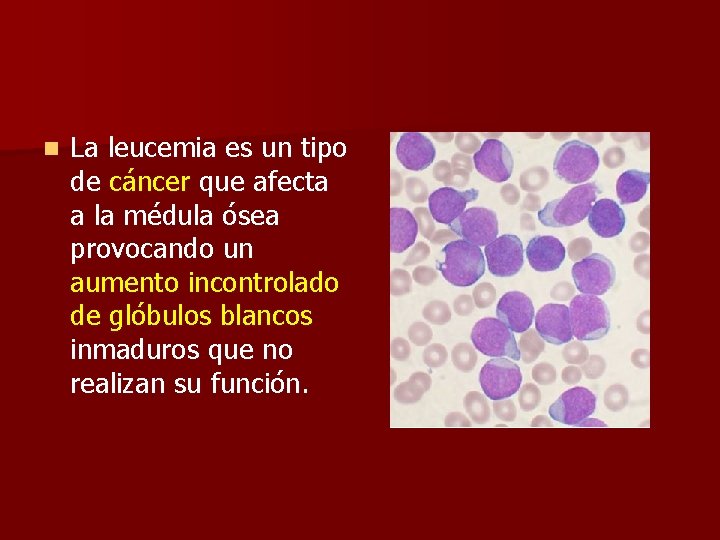
n La leucemia es un tipo de cáncer que afecta a la médula ósea

EL SISTEMA CIRCULATORIO n Nuestro cuerpo est formado

- Slides: 42
EL SISTEMA CIRCULATORIO
n Nuestro cuerpo está formado por unos cien billones de células vivas. La mayoría de ellas vive en posiciones fijas y alejadas del mundo exterior. n Por eso los nutrientes y el oxígeno que necesitan tienen que llegar a ellas por medio de un sistema de circulación. n Por la misma razón las sustancias de desecho que producen tienen que ser evacuadas por un sistema de circulación.
Por medio del sistema circulatorio nuestras células obtienen del mundo exterior las sustancias que necesitan para vivir (nutrientes y oxígeno) y expulsan al mundo exterior los desechos que producen al vivir (urea y dióxido de carbono).
EL S. C. ESTÁ FORMADO POR: UN LÍQUIDO: LA SANGRE. UN CIRCUITO CERRADO DE TUBOS: LOS VASOS SANGUÍNEOS. UNA BOMBA QUE MUEVE EL LÍQUIDO DENTRO DEL CIRCUITO: EL CORAZÓN.
LA SANGRE n Es el líquido que circula en el interior de los vasos sanguíneos impulsado por los latidos del corazón. n Los varones adultos tienen de 5 a 6 litros de sangre y las mujeres de 4 a 5 litros dependiendo del peso y de la altura.
GLÓBULOS ROJOS 5. 000 por mm 3 PLAQUETAS 250. 000 por mm 3 COMPOSICIÓN DE LA SANGRE GLÓBULOS BLANCOS 8. 000 por mm 3 54 % 1% 45 % PLASMA GLÓBULOS BLANCOS Y PLAQUETAS GLÓBULOS ROJOS
n EL PLASMA ES EL LÍQUIDO QUEDA CUANDO RETIRAMOS LAS CÉLULAS SANGUÍNEAS. n EL 54 % DEL VOLUMEN DE LA SANGRE ES PLASMA. PRINCIPALES COMPONENTES DEL PLASMA GRAMOS POR LITRO DE PLASMA AGUA 910 SALES 9 PROTEÍNAS 70 LÍPIDOS 6 GLUCOSA 1 UREA 0, 2
MÉDULA ÓSEA ROJA Un glóbulo rojo vive unos 120 días y un glóbulo blanco 1 día. Para sustituirlos, la médula ósea roja produce cada día unos 200 millones de glóbulos blancos y 200. 000 millones de glóbulos rojos.
Los glóbulos rojos transportan el oxígeno El plasma transporta nutrientes, sal, CO 2 y sustancias de desecho LA FUNCIÓN PRINCIPAL DE LA SANGRE ES EL TRANSPORTE DE SUSTANCIAS DE UNAS PARTES A OTRAS DEL CUERPO.
Molécula de hemoglobina Un glóbulo rojo tiene 300 millones de moléculas de hemoglobina. n Cada una contiene 4 átomos de hierro que sirven para fijar el oxígeno. n
Cantidad normal Cantidad con anemia La anemia se produce por falta de hierro en la alimentación. n La cantidad de glóbulos rojos es más baja de lo normal. n ¿Cuáles son los síntomas y por qué se producen? n
3 1 2 Los glóbulos blancos defienden al cuerpo frente a las infecciones. n Describe lo que está sucediendo en 1, 2 y 3. n
n CUANDO SE PRODUCE UNA ENFERMEDAD INFECCIOSA, ¿QUÉ SUCEDE CON LA CANTIDAD DE GLÓBULOS BLANCOS EN LA SANGRE? ¿POR QUÉ?
n La leucemia es un tipo de cáncer que afecta a la médula ósea provocando un aumento incontrolado de glóbulos blancos inmaduros que no realizan su función.
La coagulación de la sangre es vital para detener las hemorragias. Las plaquetas son necesarias para que se inicie este proceso.
HEMORRAGIA = salida de sangre debida a la rotura de un vaso. El COAGULO forma un tapón que evita la hemorragia.
n La hemofilia es una enfermedad genética (hereditaria) en la que la coagulación de la sangre se produce deficientemente.
LOS VASOS SANGUÍNEOS Son los conductos por los que circula la sangre. n Hay tres tipos: ARTERIA n – Arterias – Venas – Capilares CAPILARES VENA
Epitelio plano LAS ARTERIAS Capa de músculo liso y fibras elásticas Capa de colágeno LLEVAN LA SANGRE DESDE EL CORAZÓN HASTA LOS ÓRGANOS. LA SANGRE CIRCULA A ALTA PRESIÓN Y A PULSOS. SU PARED ES GRUESA Y ELÁSTICA.
¿POR QUÉ TIENEN PULSO LAS ARTERIAS? ¿QUÉ PASA CON EL PULSO CUANDO HACEMOS EJERCICIO?
n LA TENSIÓN: Es la presión a la que circula la sangre dentro de las arterias. Tiene dos valores, uno máximo y otro mínimo. Por ejemplo: 12/8.
La hipertensión puede causar graves trastornos de salud como la rotura de vasos sanguíneos. Producen tensión alta el consumo de alcohol, el tabaquismo, el estrés, la obesidad y la alimentación con exceso de colesterol.
ARTERIA NORMAL PLACA MUY DESARROLLADA POCO PASO DE SANGRE n FASE INICIAL UN COAGULO PUEDE OBSTRUIR LA ARTERIA LA ARTERIOSCLEROSIS. Es un endurecimiento con pérdida de elasticidad de las arterias que se produce al depositarse colesterol y grasas formando placas.
LAS VENAS CONDUCEN LA SANGRE DESDE LOS ÓRGANOS AL CORAZÓN. SUS PAREDES SON MÁS FINAS QUE LAS DE LAS ARTERIAS. Válvula LA SANGRE CIRCULA A BAJA PRESIÓN. POSEEN VÁLVULAS QUE IMPIDEN EL RETROCESO DE LA SANGRE. Capa muscular Epitelio plano Corte transversal de una vena
UNA VÁLVULA ES UN DISPOSITIVO QUE PERMITE LA CIRCULACIÓN EN UN SENTIDO PERO NO EN EL CONTRARIO.
¿POR QUÉ NO TIENEN PULSO LAS VENAS? ¿QUÉ HACE SUBIR A LA SANGRE DESDE LAS VENAS DE LAS PIERNAS HASTA EL CORAZÓN?
n LAS VARICES: Se ensanchan y extienden las venas de las piernas. Las válvulas se separan y la sangre puede retroceder.
LOS CAPILARES Son los vasos de menor diámetro. n Su pared es muy fina y la sangre circula muy despacio, lo que permite los intercambios entre la sangre y las células. n
Los capilares forman redes que conectan una arteria con una vena. n Indica mediante flechas el sentido de circulación de la sangre. n ¿Por qué cambia el color con el que se representa la sangre al pasar por la red capilar? n
¿Qué modificaciones experimenta la sangre a su paso por cada una de estas redes capilares?
EL CORAZÓN Vista anterior del corazón al que se ha retirado el pericardio. n Es la bomba que impulsa la sangre por los vasos sanguíneos. n Late unas 100. 000 veces al día, unos 2. 700 millones de veces a lo largo de una vida de ochenta años.
n Sus paredes son de tejido muscular (miocardio). Está hueco y dividido en cuatro cavidades: n Dos aurículas: n AI AD – Aurícula derecha (AD) – Aurícula izquierda (AI) VI VD n Dos ventrículos: – Ventrículo derecho (VD) – Ventrículo izquierdo (VI)
1 2 2 1 EL CORAZÓN TIENE DOS PARES DE VÁLVULAS QUE EVITAN EL RETROCESO DE LA SANGRE: 1. VÁLVULAS AURICULO-VENTRICULARES 2. VÁLVULAS SEMILUNARES
n EL LATIDO DEL CORAZÓN CONSTA DE TRES FASES: – Sístole auricular – Sístole ventricular – Diástole
n ¿En qué se diferencian las sangres del lado derecho e izquierdo del corazón? ¿Por qué?
Arteria aorta Arteria pulmonar Vena cava superior Venas pulmonares Vena cava inferior
VI VD n ¿Qué sucedería si el tabique separa los dos ventrículos estuviera perforado?
CIRCUITO PULMONAR: Ventrículo derecho Circuito pulmonar Arterias pulmonares Pulmones Venas pulmonares Aurícula izquierda
CIRCUITO GENERAL: Ventrículo izquierdo Arteria aorta Órganos Circuito general Venas cavas Aurícula derecha
Las paredes musculares del corazón se llaman miocardio. n El miocardio recibe sangre con oxígeno y nutrientes por las arterias coronarias. n
n En las arterias coronarias se pueden formar placas de colesterol y grasa, dificultando el normal suministro de oxígeno al miocardio. ¿Cómo responde el corazón a esta situación?
n INFARTO DE MIOCARDIO. Sucede cuando se obstruye alguna arteria coronaria interrumpiéndose el riego sanguíneo a una parte más o menos extensa del tejido muscular cardiaco.